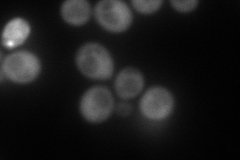
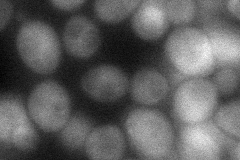

View description
Meiosis-specific component of the spindle pole body, part of the leading edge protein (LEP) coat, forms a ring-like structure at the leading edge of the prospore membrane during meiosis II
Localization:
Intensity:
Fold change:
Significance:
-
C’ GFP library in SD

below threshold13.81 -
N' NOP1pr-GFP in SD

cytosol143.382 -
N' TEF2pr-mCherry in SD
cytosol198.894 -
N' NATIVEpr-GFP in SD

below threshold19.9649 -
N' TEF2pr-VC and Cyto-VN in SD
cytosol55.0976 -
C’ GFP library in SD+DTT

cytosol17.231.24No -
C’ GFP library in SD+H2O2

cytosol19.121.38No -
C’ GFP library in Starvation Media

cytosol27.131.96No -
C’ GFP library on the background of Pup2-DaMP

below threshold -
C’ GFP library on the background of CCT mutant

below threshold16.30871.18065No
